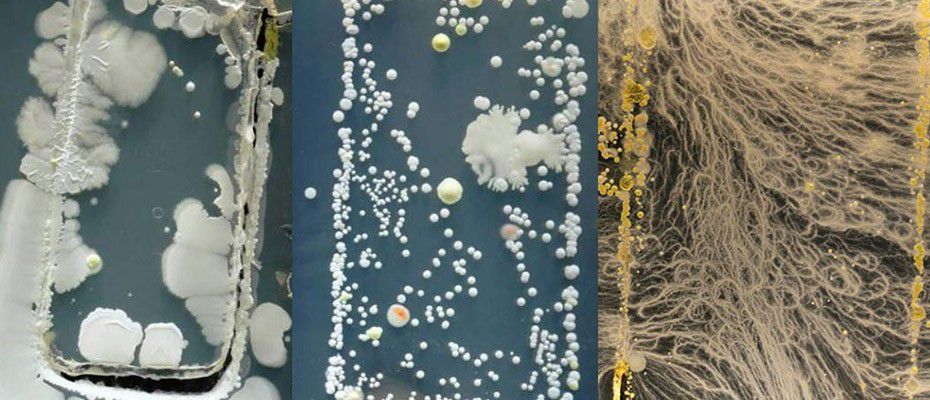

Il nous suit dans notre plus grande intimité, même dans les toilettes. Ce qui se trouve être une très mauvaise habitude qui peut avoir un impact négatif sur notre santé.
Voici trois raisons qui vont vous faire cesser cette habitude :
- La propagation de nombreuses bactéries
D’après une étude britannique, les téléphones portables accumulent plus de saleté que le siège des toilettes. Il a été démontré que les Smartphones étaient couverts d’E.coli, des bactéries nocives qui peuvent déclencher des problèmes intestinaux, comme les intoxications alimentaires.
Selon toujours cette étude, ces bactéries proviendraient d’un déficit important d’hygiène lié au fait de ne pas se laver systématiquement les mains avec du savon après chaque passage aux toilettes. Ces bactéries fécales pullulent ainsi sur les portables.
&format=jpeg)
bacteries-microbes-danger-smartphones-ecran-tactile
- Risque plus élevé d’hémorroïdes
Saviez-vous que le simple fait d’amener son portable aux toilettes peut provoquer les hémorroïdes. Vous vous demandez comment cela est possible ! Pourtant c’est logique : gardez son appareil à la main est tellement distrayant, qu’on finit par s’oublier et qu’on reste assis plus longtemps que prévu aux toilettes. Dès lors, il y a une pression qui agit sur les organes dénués de tout support au-dessus de la cuvette.
Même si des recherches n’ont pas encore prouvé cette thèse, le constat est que depuis l’introduction des Smartphones, les cas d’hémorroïdes ont augmenté.
&format=jpeg)
L'utilisation des smartphones aux toilettes provoquerait des hémoroïdes
- Augmentation de la dépendance au téléphone portable
La vocation des Smartphones surtout avec les réseaux sociaux est de vous connecter au monde extérieur. Mais, il a une caractéristique plutôt vicieuse puisqu’il finit d’une manière ou d’une autre, par créer une dangereuse dépendance.
Et le constat est que les gens ne profitent plus du moment présent avec leur famille, ami ou proche, puisqu’on a constamment le nez collé à l’appareil. On passe hélas, à côté de beaucoup d’instants précieux et de qualité.
&format=jpeg)
Smartphone-Afrique
De nombreuses personnes utilisent leur portable à longueur de journée, à table lors d’un repas familial, pendant une activité sportive ou n’importe quel évènement où les risques d’infection par voie orale subsistent. Une raison pour arrêter d’emporter les portables aux toilettes.
Il est conseillé de désinfecter régulièrement l’appareil, d’autant plus si vous avez l’habitude de l’embarquer partout avec vous.


&format=jpeg)
&format=jpeg)
&format=jpeg)
&format=jpeg)